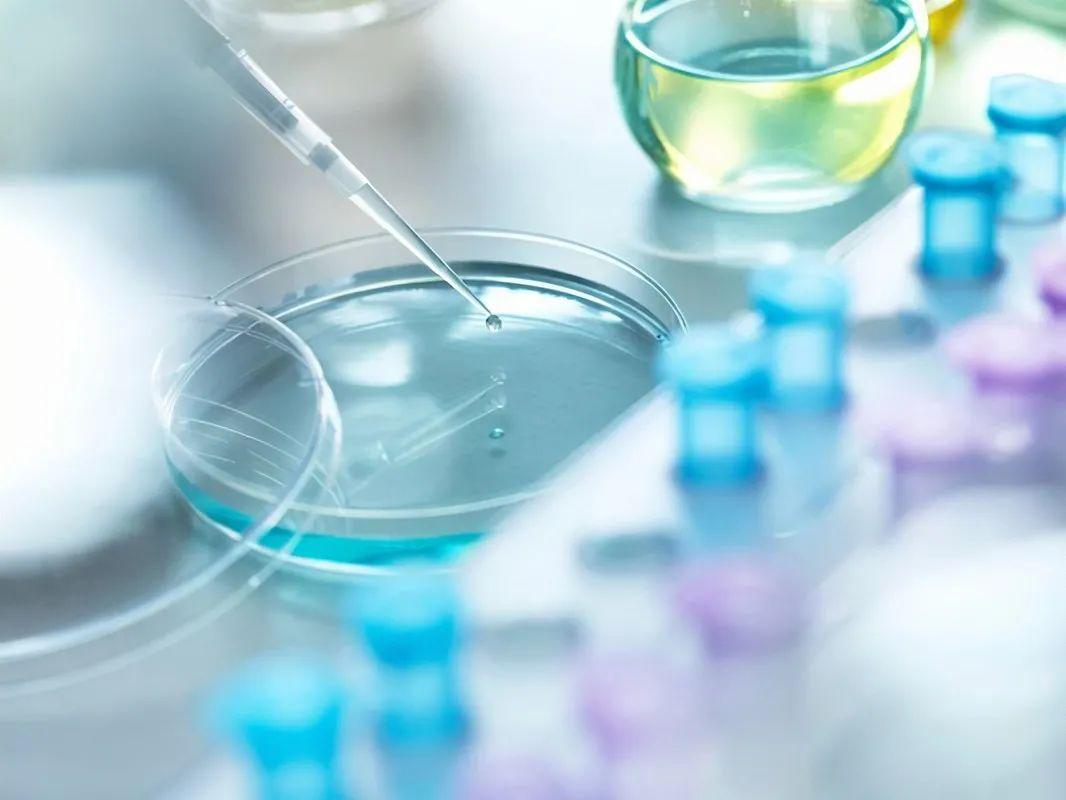

《投资时报》研究员 殷玉佳
历时两个月,广东嘉应制药股份有限公司(下称嘉应制药,002198.SZ)的内部纷争,以一方取得董事会多数席位而暂告停歇。
《投资时报》研究员注意到,嘉应制药是一家集研发、生产、销售为一体的中成药制造企业,拥有5种剂型共70多个药品品种,主要涉及咽喉类、感冒类、骨科类、风湿类中成药。其主导品种多为独家经营产品、国家中药保护品种、国家专利保护品种、国家基本用药目录品种。
据三季度报显示,该公司营收为4.03亿元,同比增长13.3%;归母净利润为449.46万元,而上年同期为亏损25.32万元;扣非归母净利润为403.83万元,上年同期仅为73.39万元。在营收增长,以及归母净利润同比增速见涨的情况下,该公司前三季度的销售净利率仅为1.12%。
嘉应制药此次闹剧被外界关注的起点是董秘被股东追打并当即报警。随后多位董事的罢免议案开始出现,上市公司也收到了深交所的多份关注函。在这背后,则是老股东深圳市老虎汇资产管理有限公司(下称老虎汇)和新进股东广东新南方医疗投资发展有限公司(下称新南方医疗)协商失败,使得公司正常管理秩序受到扰乱。
控制权之争打响
回顾嘉应制药这几个月发生的一系列事件,不得不提到两位关键人物,冯彪和朱拉伊。
2016年12月,冯彪控股的老虎汇协议受让了前第一大股东黄小彪所持有嘉应制药5720万股股份,占上市公司总股本的11.27%。老虎汇至此成为嘉应制药的第一大股东。彼时,标的股份的转让价格为18.30元/股,转让价款合计为10.47亿元。
通常,上市公司的第一大股东会顺势成为控股股东和实控人。就在冯彪入场嘉应制药没多久,控股股东就换人了。2017年4月,公司的第二大股东,即持有公司股份10.94%的陈泳洪联合数名大小个人股东签订了《一致行动人协议》。所有签下协议的股东联合控制的股份为27.96%,至此,第二大股东陈泳洪和其他股东成为了一致行动人,并一跃成为嘉应制药的控股股东。
2017年5月,上市公司即收到深交所关注函。或许是为了避免对公司的不利影响,陈泳洪等自然人股东又签署了《<一致行动人协议>之解除协议》。
《投资时报》研究员发现,在提示性公告中有这样的表述,参照2016年12月28日公司披露的《上海金茂凯德律师事务所关于公司控股股东及实际控制人认定之专项法律意见书》,老虎汇虽然作为公司第一大股东,但仍无法实际支配控制公司,公司目前无控股股东及实际控制人。
2018年7月,潜在股东中联集信投资管理有限公司(下称中联集信)以承诺增持股份为条件,与三名共计持有16.01%股份的自然人股东达成了《表决权委托协议》和《股东一致行动人协议》,以共同控制公司。但据公告披露,在该协议对公司影响一栏中有如下表述,公司目前无控股股东及实际控制人,上述《股东一致行动人协议》的签署不会形成对公司的实际控制。
据披露,上述《表决权委托协议》和《股东一致行动人协议》于2021年2月24日解除。截至协议解除之日,中联集信仅持有公司股份0.16%,未能有效通过大宗交易及集中竞价的方式完成股份增持,也未能越过老虎汇成为嘉应制药的第一大股东。至此,嘉应制药的股东权益恢复原状,公司仍然没有控股股东。
新股东出现
不过,该公司的控制权之争仍未落幕。没过多久,另一关键人物朱拉伊及其控股的新南方医疗出现。
2021年6月,嘉应制药第一大股东老虎汇与新南方医疗签订了《表决权委托协议》《附条件生效的非公开发行股份认购协议》,老虎汇持有的5720万股股份的表决权排他性的委托给新南方医疗行使,有效期为24个月,新南方医疗成为公司单一拥有表决权份额最大的股东。此外,该公司筹划向新南方医疗发行1.52亿股股份,新南方医疗以现金方式认购本次发行的全部股份,发行完成后,新南方医疗占公司总股本的持股比例、表决权比例将分别达到23.05%、31.72%。
此次交易的认购价格为定价基准日前20个交易日公司股票交易均价的80%,即5.82元/股。
据协议具体内容披露,本次交易完成后,公司控制权将发生变更,公司控股股东将变更为新南方医疗,实际控制人变更为朱拉伊。
值得注意的是,老虎汇早在2017年 2月23日将全部持有的5720万股股份(占总股本11.27%)质押给了东方证券,质押日参考股价(前复权)为15.07元。此后,前述该部分股权被兰州市中级人民法院冻结,冻结起始日期为2018年4月20日,至今未解冻。新南方医疗采用定增的方式取得嘉应制药的控制权,或许有此部分股份解冻难的原因。
2021年8月2日,据公告披露,朱拉伊获得董事会9票全票通过,成为公司董事长兼总经理,公司董事会也完成换届选举。但两方很快产生分歧,九月中旬,嘉应制药董事会两次收到了老虎汇发出的解除与新南方医疗的表决权委托协议的函件。新南方医疗拒绝解除协议,认为解除理由不符合此前签署的《表决权委托协议》。
9月22日,上市公司收到了来自深交所的关注函,要求公司进一步披露解除协议与否的原因和相关情况。至此,老虎汇与新南方医疗的矛盾才真正浮出水面。
原来今年6月,在老虎汇和新南方医疗签署《表决权委托协议》之时,冯彪与朱拉伊还签署了两份未及时公布《备忘录》。据《备忘录》显示,在董事会的九席位置中,朱拉伊方要保证冯彪方推举四席,届时由朱拉伊担任董事长,冯彪担任总经理。而老虎汇方冯彪未能担任总经理。
冯彪控股的老虎汇与朱拉伊控股的新南方医疗的矛盾一触即发。
管理乱象曝光
8月5日,也许是为了缓解矛盾,嘉应制药的新任董事长朱拉伊提议由公司股东黄利兵担任执行总经理。老虎汇仍持反对意见,并坚决要求解除《表决权委托协议》。
据公司独董肖义南表示,他曾收到董秘徐胜利的《控告函》。相关信息显示,在9月8日晚10时许,黄利兵以“喝茶”为由,去到四楼高管宿舍要请公司董事、董事会秘书徐胜利到其三楼办公室喝茶,进入办公室后将门反锁,黄利兵有针对性地将对股东的不满撒在董事会秘书身上,对公司董事兼董秘徐胜利动手。随后徐胜利跑出黄利兵办公室后借用保安手机拨打110报警。徐胜利称黄利兵动手的原因是因为老虎汇不同意他担任公司总经理。
董秘被追打事件经多家媒体报道迅速成为市场焦点,公司的控制权之争也完全浮出水面。而从公司角度来看,徐胜利作为公司信息披露的第一义务人,《备忘录》的曝光与其不无关系。新南方医疗认为此举破坏了此前协议好的定增计划的顺利推进,并给公司造成了负面影响,让外界窥见了嘉应制药内部管理的乱象。
10月15日,在公司第六届董事会第二次临时会议上,徐胜利的董秘职务被解除,理由为徐胜利擅自回复深交所关于《表决权委托协议》是否解除的关注函,严重妨碍了公司信息披露工作,干扰了公司董事会的正常工作秩序。
此后,老虎汇和新南方医疗再次各自出招,11月16日召开的公司第五次临时股东大会是交锋的焦点。
其中,老虎汇提交了三个提案,分别是罢免非独立董事朱拉伊和黄晓亮,罢免独立董事徐驰。
此次临时股东大会上,还有两个罢免提案,分别是罢免非独立董事徐胜利和独立董事肖义南。这两个提案的提交方为股东大连东涛投资有限公司(下称大连东涛)。
《投资时报》研究员查阅嘉应制药的往期股东发现,大连东涛是通过连续增持上市公司股票新晋的股东方。嘉应制药的2021年三季报显示,大连东涛为公司第九大股东,持股数量为388万股,占公司总股本的比例0.76%,是今年三季度的新晋股东。
根据公告,截至10月29日盘后,大连东涛持有嘉应制药1599万股股份,占公司总股本的3.15%。这意味着,10月期间,大连东涛大手笔增持了嘉应制药1211万股,新晋成为公司持股3%以上股东,这才令其具备提出临时提案的资格。
对于大连东涛的连续增持,但未触达5%股份公开披露线的问题,嘉应制药在回复深交所的关注函中表示,大连东涛控股股东钱云冰平时对嘉应制药股票有所关注,且在嘉应制药公告对新南方医疗的消息之后,研究了定增对象控制方新南方医疗的中医药产业优势及朱拉伊的中医药专家的个人背景,对其控制的新南方医疗定增嘉应制药的前景看好,故大量买入嘉应制药的股票。
业绩表现不佳
由于大连东涛突如其来地提出了两项罢免议案,嘉应制药再次收到了来自深交所的关注函。
对于大连东涛短期内增持公司股票后立即提出罢免两名公司董事的原因,大连东涛称,其与公司现任董监高、其他股东均不存在关联或一致行动关系。罢免议案是因为徐胜利和肖义南不具备担任公司董事的资格。
在临时议案中,大连东涛称,徐胜利为专职律师,担任公司董事属于违规兼职。
其次,肖义南与老虎汇的实控人冯彪存在紧密联系,不具备担任公司独立董事的资格。肖义南从2016年1月至今一直在上市公司海南椰岛担任独立董事,而海南椰岛是嘉应制药第一大股东老虎汇的实际控制人冯彪实际控制的另一家上市公司。大连东涛还称,肖义南在独董意见中具有偏向性得披露了董秘被追打一事,给嘉应制药带来了严重的负面影响。
在11月16日的临时股东大会上,老虎汇提出的三件罢免提案均未获通过。而大连东涛提出的两件罢免案都获得了通过。徐胜利和肖义南的董事职务被罢免,朱拉伊、黄晓亮和徐驰继续担任公司董事。
《投资时报》研究员注意到,2017年—2020年,公司营收分别为4.69亿元、5.37亿元、5.01亿元和5.45亿元,同比增长分别为4.03%、14.72%、-6.79%和8.84%;归母净利润分别为-2.15亿元、0.36亿元、-1.22亿元和0.2亿元,同比增长分别为-489.26%、116.71%、-440.55%和116.24%。
可以看到,在嘉应制药处于无实控人的时间段内,总体财务表现不佳。尤其值得注意的是,该公司的销售费用高企。2017年—2020年,公司的销售费用分别为2.35亿元、2.766亿元、3.06亿元和3.0亿元,占总营收的比重分别为50.27%、51.34%、61.15%和55.06%。据三季度报显示,销售费用高达2.43亿元,占总营收比重再次回到60%水平线上,为60.24%。
再看嘉应制药近几年来在二级市场上的表现,2016年至今,公司股价从最高点15.95元/股,一路震荡下跌,截至11月26日,公司收盘价为8.11元/股。
截至嘉应制药第五次临时股东大会,朱伊拉控股的新南方医疗暂时在董事会上占上风。在11月23日的第六届董事会第四次临时会议上,包括聘请保荐机构等几项议案均是以6票同意,1票反对,0票弃权通过。
嘉应制药2016年至今营业总成本(万元)

数据来源:Wind



相关文章